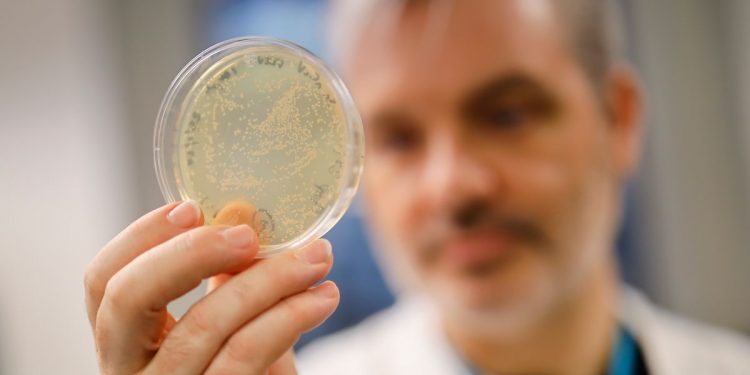
teacher being tested

Schoolchildren throughout town are being warned to remain house if they’ve returned from areas affected by coronavirus.
Pupils at a rising variety of London colleges are being quarantined over virus fears, whereas a number of companies have despatched employees house.
Up to now pupils from colleges in a number of elements of London whereas a minimum of three companies have despatched employees house, together with oil firm Chevron which closed its office of 300 workers in Canary Wharf, with studies a employee displayed signs.
The most recent faculty to ship out a warning to pupils is Latchmere Faculty in Kingston. One mother or father on the faculty has shared with MyLondon a message that states a trainer has been informed to self quarantine.
The e-mail revealed the trainer has been left feeling unwell, and as her son had returned from a current faculty ski journey to Northern Italy, the college determined it was greatest for her to not return to work till she had been examined.
The assertion reads: “She can be attending the screening pod right now and won’t return to highschool till she has a transparent end result.”
Latchmere Faculty has been approached for remark.
A faculty in Dulwich has additionally been pressured to shut after pupils fell unwell after a visit in Northern Italy.
That is the primary faculty within the capital to close over virus fears.
Italy has change into Europe’s epicentre of the virus with 300 circumstances and 11 deaths to this point. The northern areas of Lombardy and Veneto have been worst affected.
For extra information and updates about your native space, put your postcode in our helpful widget under:
Have fears of coronavirus affected your office or your kid’s faculty? Please get in contact with any info it might be useful to share with our readers by emailing mylondonnewsdesk@reachplc.com
Observe our dwell weblog under for the most recent updates as we get them.
Author: " -- www.mylondon.news "